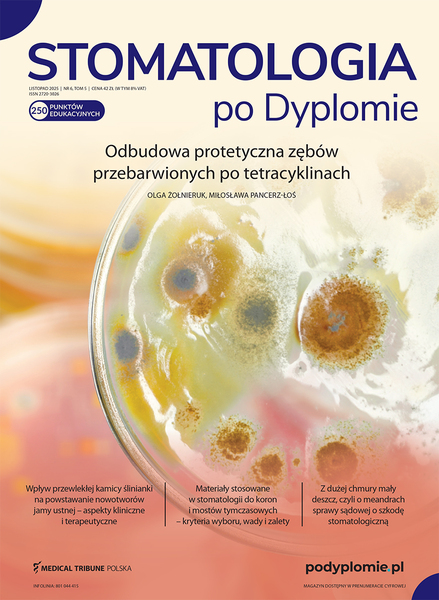

Stomatologia po Dyplomie Nr 06 (listopad) / 2025
Łódzka Izba Lekarska>
Spis treści
Słowo wstępne
-
Od bieli po czerń
Dostęp Otwarty
dr hab. n. med. Elżbieta Bołtacz-Rzepkowska, prof. UM w Łodzi
Aktualności naukowe
-
Najnowsze badania
Porównanie skuteczności odbudowy ubytków przyszyjkowych niepróchnicowego pochodzenia za pomocą kompozytu i materiałów szkłojonomerowych Kup dostęplek. dent. Weronika Wiśniewska-Oficjalska
-
Najnowsze badania
Zastosowanie robotów w stomatologii Kup dostęplek. dent. Weronika Wiśniewska-Oficjalska
-
Najnowsze badania
Sedacja farmakologiczna w leczeniu pacjentów młodocianych Kup dostęplek. dent. Weronika Wiśniewska-Oficjalska
-
Najnowsze badania
Fenotyp dziąsła a sukces leczenia Kup dostęplek. dent. Weronika Wiśniewska-Oficjalska
Temat numeru
-
Odbudowa protetyczna zębów przebarwionych po tetracyklinach
Kup dostęp
lek. dent. Olga Żołnieruk
dr n. med. Miłosława Pancerz-Łoś
Opis przypadku
-
Rola natychmiastowych protez całkowitych w procesie regeneracji podłoża protetycznego w odbudowie implantoprotetycznej
Kup dostęp
lek. dent. Aleksandra Sochacka
Stomatologia zachowawcza
-
Leczenie stanów zapalnych miazgi zębów mlecznych
Kup dostęp
lek. dent. Anna Haładyj
Stomatologia interdyscyplinarna
-
Wpływ przewlekłej kamicy ślinianki na powstawanie nowotworów jamy ustnej – aspekty kliniczne i terapeutyczne
Dostęp Otwarty
dr n. med. Monika Rutkowska1
dr n. med. Aleksandra Jaroń-Prażuch1
prof. dr hab. n. med. Grzegorz Trybek1,2
Materiałoznawstwo
-
Materiały stosowane w stomatologii do koron i mostów tymczasowych – kryteria wyboru, wady i zalety
Kup dostęp
lek. dent. Barbara Imiołczyk
lek. dent. Jakub Bąba
Przegląd piśmiennictwa
-
Niedobory składników odżywczych u dzieci a powikłania w obrębie jamy ustnej
Kup dostęp
dr hab. n. med. Maria Mielnik-Błaszczak, prof. UM w Lublinie
dr n. med. Dorota Krawczyk
Zarządzanie praktyką
-
Kluczowe wskaźniki efektywności pracy zespołu stomatologicznego – co naprawdę warto mierzyć?
Kup dostęp
dr Adrian Majewski
Prawo
-
Z dużej chmury mały deszcz, czyli o meandrach sprawy sądowej o szkodę stomatologiczną
Kup dostęp
Natalia Strzelec1
radca prawny Paweł Strzelec2